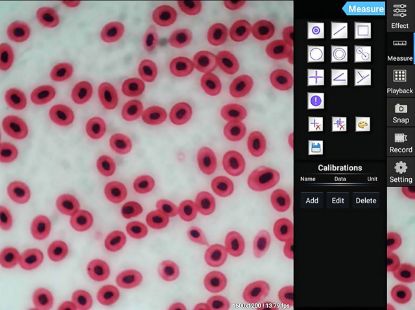
Kern 5MP Tablet Camera 9.7” LCD Touchscreen WLAN Bluetooth HDMI USB 2.0 Connection_1426690

The Kern 5MP Tablet Camera features an integrated 5-megapixel camera with live image transmission to the 9.7” Android tablet touchscreen. It supports image and video capture for efficient documentation and includes simple measurement tools to enhance workflow.
Product Features
- Integrated 5MP camera for live transmission, image, and video capture
- 9.7” LCD touchscreen for intuitive control and viewing
- Connectivity via WLAN, Bluetooth, HDMI, and USB 2.0 for versatile use
- Measurement functions including distance, area, angle, and manual counting
- Automatic white balance and contrast adjustment for optimal image quality
Benefits
- Enables efficient documentation with image and video capture
- User-friendly touchscreen interface enhances ease of operation
- Flexible connectivity options for seamless integration into workflows
- Measurement tools facilitate quick and accurate analysis
- Automatic adjustments improve image clarity and consistency
Why Choose the Kern 5MP Tablet Camera?
Ideal for professionals requiring high-quality imaging combined with measurement capabilities, this tablet camera supports efficient documentation and flexible connectivity in various applications.